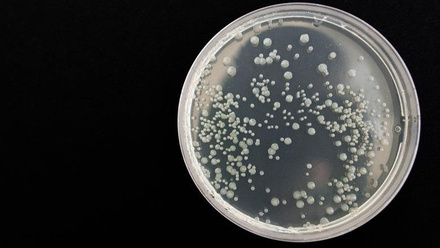
7691_bacteria359956_1280_932568_crop.jpg

Environment
The Environment research area at the Microbes and Social Equity (MSE) group investigates the dynamic interactions between microbial communities and various ecosystems. Recognizing the profound impact of environmental changes on microbial dynamics, our research delves into how these changes affect and are affected by microbial activities, especially under the pressing conditions of climate change.
Objectives and Impact
The Environment research at MSE aims to:
- Understand and elucidate the environmental roles of microbes and their responses to global environmental changes.
- Promote sustainable environmental practices and policies by integrating microbial science into ecological conservation efforts.
- Address environmental justice by exploring how microbial research can reduce disparities and enhance access to healthy environments.
Highlighted Research and Discussions